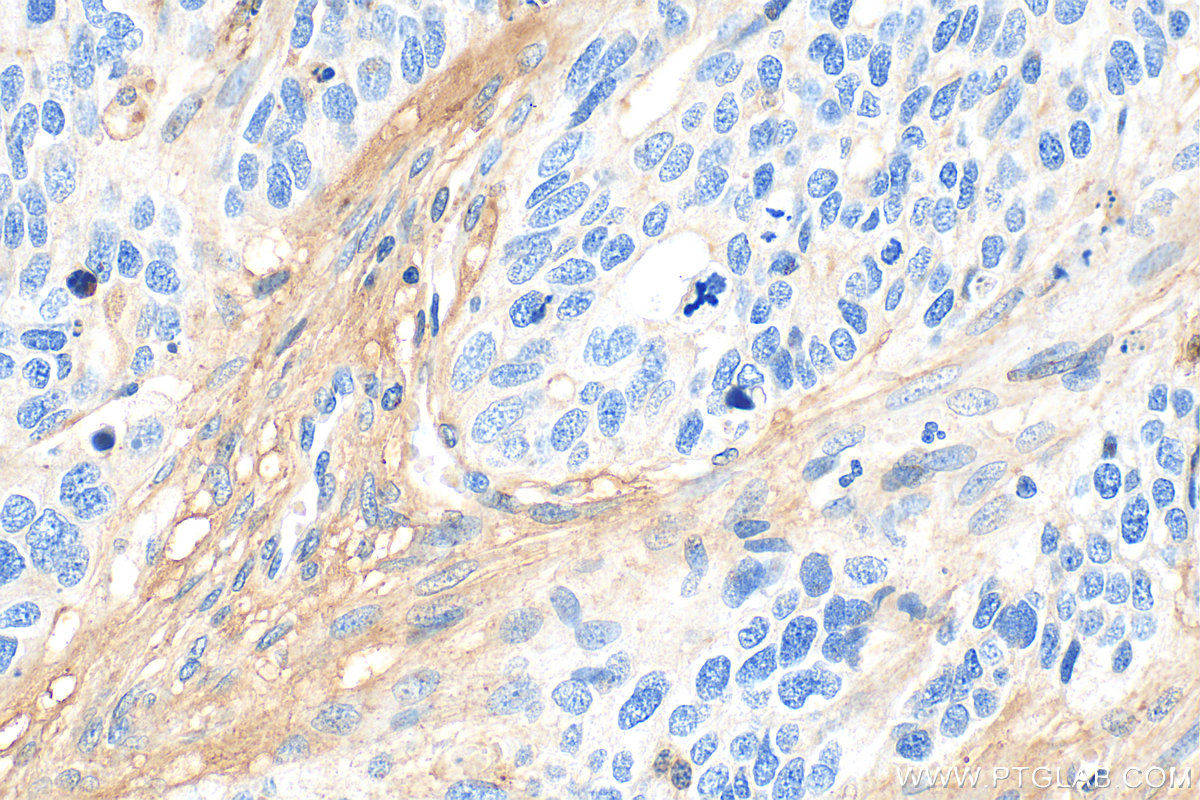
Immunohistochemical analysis of paraffin-embedded human ovary tumor tissue slide using 25474-1-AP (CTGF antibody) at dilution of 1:400 (under 40x lens). Heat mediated antigen retrieval with Tris-EDTA buffer (pH 9.0). IHC staining of human ovary tumor using 25474-1-AP

验证数据展示
经过测试的应用
| Positive WB detected in | HUVEC cells, HeLa cells, MG-63 cells, U2OS cells |
| Positive IP detected in | HUVEC cells |
| Positive IHC detected in | human ovary tumor tissue, mouse colon tissue Note: suggested antigen retrieval with TE buffer pH 9.0; (*) Alternatively, antigen retrieval may be performed with citrate buffer pH 6.0 |
推荐稀释比
| 应用 | 推荐稀释比 |
|---|---|
| Western Blot (WB) | WB : 1:1000-1:8000 |
| Immunoprecipitation (IP) | IP : 0.5-4.0 ug for 1.0-3.0 mg of total protein lysate |
| Immunohistochemistry (IHC) | IHC : 1:200-1:800 |
| It is recommended that this reagent should be titrated in each testing system to obtain optimal results. | |
| Sample-dependent, Check data in validation data gallery. | |
产品信息
25474-1-AP targets CTGF in WB, IHC, IF, IP, ELISA applications and shows reactivity with human, mouse samples.
| 经测试应用 | WB, IHC, IP, ELISA Application Description |
| 文献引用应用 | WB, IHC, IF |
| 经测试反应性 | human, mouse |
| 文献引用反应性 | human, mouse, rat, pig, canine, goat |
| 免疫原 |
Peptide 种属同源性预测 |
| 宿主/亚型 | Rabbit / IgG |
| 抗体类别 | Polyclonal |
| 产品类型 | Antibody |
| 全称 | connective tissue growth factor |
| 别名 | CCN family member 2, CCN2, Cellular communication network factor 2, HCS24, Hypertrophic chondrocyte-specific protein 24 |
| 计算分子量 | 38 kDa |
| 观测分子量 | 35 kDa |
| GenBank蛋白编号 | NM_001901 |
| 基因名称 | CTGF |
| Gene ID (NCBI) | 1490 |
| RRID | AB_2918089 |
| 偶联类型 | Unconjugated |
| 形式 | Liquid |
| 纯化方式 | Antigen affinity purification |
| UNIPROT ID | P29279 |
| 储存缓冲液 | PBS with 0.02% sodium azide and 50% glycerol, pH 7.3. |
| 储存条件 | Store at -20°C. Stable for one year after shipment. Aliquoting is unnecessary for -20oC storage. |
背景介绍
CTGF, also known as CCN2, is a member of the CCN family of matricellular proteins. CTGF, a cysteine-rich, matrix-associated, heparin-binding protein, is widely expressed in various human tissues and organs. CTGF has important roles in many biological processes, including cell adhesion, migration, proliferation, angiogenesis, skeletal development, and tissue wound repair, and is critically involved in fibrotic disease and several forms of cancers.
实验方案
| Product Specific Protocols | |
|---|---|
| IHC protocol for CTGF antibody 25474-1-AP | Download protocol |
| IP protocol for CTGF antibody 25474-1-AP | Download protocol |
| WB protocol for CTGF antibody 25474-1-AP | Download protocol |
| Standard Protocols | |
|---|---|
| Click here to view our Standard Protocols |
发表文章
| Species | Application | Title |
|---|---|---|
EMBO J MST2 methylation by PRMT5 inhibits Hippo signaling and promotes pancreatic cancer progression | ||
Acta Pharmacol Sin Urolithin A promotes atherosclerotic plaque stability by limiting inflammation and hypercholesteremia in Apolipoprotein E-deficient mice | ||
J Orthop Translat Oxidative stress activates YAP/TEAD1/NCOA4 axis to promote ferroptosis of endplate chondrocytes and aggravate intervertebral disc degeneration | ||
Oxid Med Cell Longev Cigarette Smoke Exposure Increases Glucose-6-phosphate Dehydrogenase, Autophagy, Fibrosis, and Senescence in Kidney Cells In Vitro and In Vivo. | ||
Front Bioeng Biotechnol Effect of stem cell conditional medium-loading adhesive hydrogel on TGF-β1-induced endometrial stromal cell fibrosis |